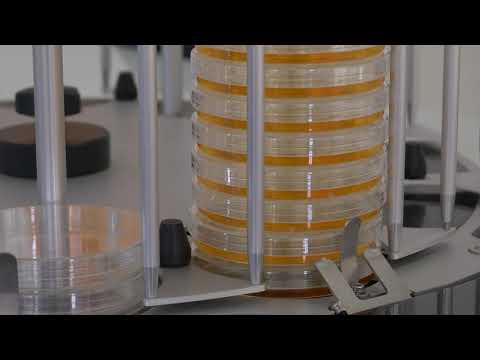

Показано: 5 из 5

Пробоотборники воздуха Airwel, ABE, автотестирование, англ., 2019 г.
10.09.2022

Отбор проб воздуха – Airwel, ABE, англ., 2019 г.
10.09.2022
Разливочная станция Distriwel 440, ABE, англ., 2020 г.
17.09.2021

Средоварка Mediawel 30, ABE, англ., 2020 г.
17.09.2021

Средоварка Mediawel 10, ABE, англ., 2020 г.
17.09.2021